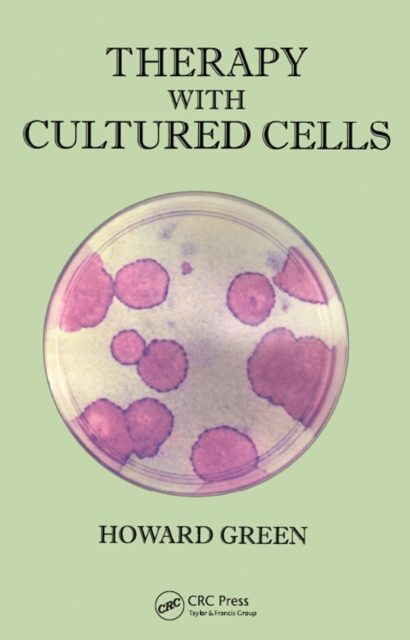
Therapy with cultured cells

Catalogue Search | MBRL
Search Results Heading
Explore the vast range of titles available.
MBRLSearchResults
-
DisciplineDiscipline
-
Is Peer ReviewedIs Peer Reviewed
-
Item TypeItem Type
-
SubjectSubject
-
YearFrom:-To:
-
More FiltersMore FiltersSourceLanguage
Done
Filters
Reset
1,100
result(s) for
"Green, Howard"
Sort by:
Correlates of physical activity and sedentary behavior among cancer survivors and cancer-free women: The Women’s Health Accelerometry Collaboration
by
Evenson, Kelly R.
,
LaCroix, Andrea Z.
,
Schilsky, Samantha
in
Accelerometry
,
Analysis
,
Behavior
2024
Describing correlates of physical activity (PA) and sedentary behavior (SB) among postmenopausal cancer survivors can help identify risk profiles and can be used to support development of targeted interventions to improve PA and reduce SB in this population.
To describe PA/SB and identify correlates of PA/SB among cancer and cancer-free post-menopausal women.
Women from the Women's Health Study (N = 16,629) and Women's Health Initiative/Objective Physical Activity and Cardiovascular Health Study (N = 6,079) were asked to wear an accelerometer on the hip for 7 days. Multiple mixed-effects linear regression models were used to identify sociodemographic-, health-, and chronic condition-related correlates (independent variables) associated with PA and SB (dependent variables) among women with (n = 2,554) and without (n = 20,154) a history of cancer. All correlates were mutually adjusted for each other.
In unadjusted analyses, women with a history of cancer took fewer mean daily steps (4,572 (standard deviation 2557) vs 5,029 (2679) steps/day) and had lower mean moderate-to-vigorous PA (74.9 (45.0) vs. 81.6 (46.7) minutes/day) than cancer-free women. In adjusted analyses, for cancer and cancer-free women, age, diabetes, overweight, and obesity were inversely associated with all metrics of PA (average vector magnitude, time in moderate-to-vigorous PA, step volume, time at ≥40 steps/minutes, and peak 30-minute step cadence). In unadjusted analyses, mean SB was similar for those with and without cancer (529.7 (98.1) vs. 521.7 (101.2) minutes/day). In adjusted analyses, for cancer and cancer-free women, age, diabetes, cardiovascular disease, current smoking, overweight, and obesity were positive correlates of SB, while Black or Hispanic race/ethnicity, weekly/daily alcohol intake, and excellent/very good/good self-rated health were inverse correlates of SB.
Several sociodemographic, health, and chronic conditions were correlates of PA/SB for postmenopausal women with and without cancer. Future studies should examine longitudinal relationships to gain insight into potential determinants of PA/SB.
Journal Article
Therapy with cultured cells
2019
In this book the author describes the discoveries in his laboratory that led to therapy with cultured cells. The first cultured cell type used for therapy was the keratinocyte of the epidermis, for the treatment of burns. Subsequent developments led to the use of cultured cells for the treatment of diseases of the eye, of the joints and of other diseases. Cultured cells for therapy are now being prepared by industries in the US, Japan and Korea and are used in the aforesaid countries, as well as in France, Sweden and Greece, for the treatment of disease.
Lysine-specific demethylase 2A (KDM2A) normalizes human embryonic stem cell derived keratinocytes
2012
Studies on human lysine-specific demethylase 2A (KDM2A) by others have recently begun. To date, the demethylase activity has been known to reduce expression of genes and eventually inhibit proliferation of cells. However, while attempting to improve proliferation of hES-cell–derived Nod keratinocytes, which grow poorly and have a short life span, we found that high expression of the KDM2A gene improves the poor proliferation of the cells. Of the four isomer cDNAs that we prepared from alternatively spliced KDM2A transcripts, only one stimulates the proliferation. This (KDM2A-N782) encodes the 782AA protein containing the JmjC, CXXC, and Ring domains, but not the F-box and AMN1 domains, unlike KDM2A, which has been studied by other groups. Our results not only show that differently spliced transcripts from a gene result in totally opposite outcomes, but also present critical evidence of the complicated activities of KDM2A, which contains all of the five domains.
Journal Article
Sex Modifies Metabolic Pathways Associated with Lipids in Untargeted Metabolomics: The Coronary Artery Risk Development in Young Adults (CARDIA) Study, 2005–2006
by
Rushing, Blake R.
,
Avery, Christy L.
,
Howard, Annie Green
in
Accuracy
,
Amino acids
,
Antilipemic agents
2025
Background: There are differences in lipid metabolism by sex that are relevant for health, but metabolic pathways are not fully understood. We investigated sex differences in cross-sectional associations between metabolic pathways identified using untargeted metabolomics and clinical lipid measures (total cholesterol [TC], triglycerides [TG], and low- and high-density lipoprotein cholesterol [LDL-c; HDL-c]) from blood plasma in the Coronary Artery Risk Development in Young Adults (CARDIA) study (Year 20; 2005–2006). Our objective was to determine whether associations between metabolic pathways and lipid measures differ by sex and to identify pathways that may underlie sex-specific mechanisms of lipid metabolism. Methods: Using data from 2169 participants, (44% women, mean age = 45, 58% White, 42% Black), we used: (1) Orthogonal partial least squares-regression (OPLS-R) to compare variation in TC, TG, LDL-c, and HDL-c explained by metabolites in men vs. women, (2) linear regression to assess sex-modification of associations between 7255 metabolite peaks and lipid measures using false discovery rate (FDR)-corrected p < 0.1, and (3) pathway enrichment analyses to identify metabolic pathways that differed by sex using Fisher’s exact test (FET) p < 0.05. Results: We found that: (1) untargeted metabolomic data reflected variation in lipid measures better for men compared to women, (2) associations between metabolite peaks and lipid measures differed by sex, and (3) 8 unique pathways differed by sex, particularly primary bile acid biosynthesis, linoleic acid metabolism, and arginine biosynthesis. Conclusions: Our findings suggest distinct lipid-associated metabolic activity by sex that points to potential mechanistic pathways.
Journal Article
Differential associations of urbanicity and income with physical activity in adults in urbanizing China: findings from the population-based China Health and Nutrition Survey 1991-2009
2015
BACKGROUND: High urbanicity and income are risk factors for cardiovascular-related chronic diseases in low- and middle-income countries, perhaps due to low physical activity (PA) in urban, high income areas. Few studies have examined differences in PA over time according to income and urbanicity in a country experiencing rapid urbanization. METHODS: We used data from the China Health and Nutrition Survey, a population-based cohort of Chinese adults (n = 20,083; ages 18-75y) seen a maximum of 7 times from 1991-2009. We used sex-stratified, zero-inflated negative binomial regression models to examine occupational, domestic, leisure, travel, and total PA in Chinese adults according to year, urbanicity, income, and the interactions among urbanicity, income, and year, controlling for age and region of China. RESULTS: We showed larger mean temporal PA declines for individuals living in relatively low urbanicity areas (1991: 500 MET-hours/week; 2009: 300 MET-hours/week) compared to high urbanicity areas (1991: 200 MET-hours/week; 2009: 125 MET-hours/week). In low urbanicity areas, the association between income and total PA went from negative in 1991 (p < 0.05) to positive by 2000 (p < 0.05). In relatively high urbanicity areas, the income-PA relationship was positive at all time points and was statistically significant at most time points after 1997 (p < 0.05). Leisure PA was the only domain of PA that increased over time, but >95 % of individuals in low urbanicity areas reported zero leisure PA at each time point. CONCLUSIONS: Our findings show changing associations for income and urbanicity with PA over 18 years of urbanization. Total PA was lower for individuals living in more versus less urban areas at all time points. However, these differences narrowed over time, which may relate to increases in individual-level income in less urban areas of China with urbanization. Low-income individuals in higher urbanicity areas are a particularly critical group to target to increase PA in China.
Journal Article
A systematic scoping review of latent class analysis applied to accelerometry-assessed physical activity and sedentary behavior
by
Evenson, Kelly R.
,
Howard, Annie Green
,
Kebede, Michael
in
Accelerometers
,
Accelerometry
,
Analysis
2024
Latent class analysis (LCA) identifies distinct groups within a heterogeneous population, but its application to accelerometry-assessed physical activity and sedentary behavior has not been systematically explored. We conducted a systematic scoping review to describe the application of LCA to accelerometry.
Comprehensive searches in PubMed, Web of Science, CINHAL, SPORTDiscus, and Embase identified studies published through December 31, 2021. Using Covidence, two researchers independently evaluated inclusion criteria and discrepancies were resolved by consensus. Studies with LCA applied to accelerometry or combined accelerometry/self-reported measures were selected. Data extracted included study characteristics and both accelerometry and LCA methods.
Of 2555 papers found, 66 full-text papers were screened, and 12 papers (11 cross-sectional, 1 cohort) from 8 unique studies were included. Study sample sizes ranged from 217-7931 (mean 2249, standard deviation 2780). Across 8 unique studies, latent class variables included measures of physical activity (100%) and sedentary behavior (75%). About two-thirds (63%) of the studies used accelerometry only and 38% combined accelerometry and self-report to derive latent classes. The accelerometer-based variables in the LCA model included measures by day of the week (38%), weekday vs. weekend (13%), weekly average (13%), dichotomized minutes/day (13%), sex specific z-scores (13%), and hour-by-hour (13%). The criteria to guide the selection of the final number of classes and model fit varied across studies, including Bayesian Information Criterion (63%), substantive knowledge (63%), entropy (50%), Akaike information criterion (50%), sample size (50%), Bootstrap likelihood ratio test (38%), and visual inspection (38%). The studies explored up to 5 (25%), 6 (38%), or 7+ (38%) classes, ending with 3 (50%), 4 (13%), or 5 (38%) final classes.
This review explored the application of LCA to physical activity and sedentary behavior and identified areas of improvement for future studies leveraging LCA. LCA was used to identify unique groupings as a data reduction tool, to combine self-report and accelerometry, and to combine different physical activity intensities and sedentary behavior in one LCA model or separate models.
Journal Article
Marker Succession during the Development of Keratinocytes from Cultured Human Embryonic Stem Cells
2003
Human embryonic stem cells injected into scid mice produce nodules containing differentiated somatic tissues. From the trypsinized cells of such a nodule, we have recovered keratinocytes that can be grown in cell culture. The method of recovery is sensitive enough to detect small numbers of keratinocytes formed in the nodule, but for purposes of analysis, it is preferable to study the development of the entire keratinocyte lineage in culture. The principle of our analysis is the successive appearance of markers, including transcription factors with considerable specificity for the keratinocyte (p63 and basonuclin) and differentiation markers characteristic of its final state (keratin 14 and involucrin). We have determined the order of marker succession during the time- and migration-dependent development of keratinocytes from single embryoid bodies in cell culture. Of the markers we have examined, p63 was the earliest to appear in the keratinocyte lineage. The successive accumulation of later markers provides increasing certainty of emergence of the definitive keratinocyte.
Journal Article
Ancient origin of the gene encoding involucrin, a precursor of the cross-linked envelope of epidermis and related epithelia
by
Green, Howard
,
Djian, Philippe
,
Vanhoutteghem, Amandine
in
Amino Acid Sequence
,
Amino acids
,
Animals
2008
The cross-linked (cornified) envelope is a characteristic product of terminal differentiation in the keratinocyte of the epidermis and related epithelia. This envelope contains many proteins of which involucrin was the first to be discovered and shown to become cross-linked by a cellular transglutaminase. Involucrin has evolved greatly in placental mammals, but retains the glutamine repeats that make it a good substrate for the transglutaminase. Until recently, it has been impossible to detect involucrin outside the placental mammals, but analysis of the GenBank and Ensembl databases that have become available since 2006 reveals the existence of involucrin in marsupials and birds. We describe here the properties of these involucrins and the ancient history of their evolution.
Journal Article
Secular change in the association between urbanisation and abdominal adiposity in China (1993–2011)
by
Inoue, Yosuke
,
Howard, Annie Green
,
Gordon-Larsen, Penny
in
Abdomen
,
Adipose tissue
,
Adiposity
2018
BackgroundLittle attention has been paid to how the association between urbanisation and abdominal adiposity changes over the course of economic development in low-income and middle-income countries.MethodsData came from the China Health and Nutrition Survey waves 1993–2011 (seven waves). A mixed linear model was used to investigate the association between community-level urbanisation with waist-to-height ratio (WHtR; an indicator of abdominal adiposity). We incorporated interaction terms between urbanisation and study waves to understand how the association changed over time. The analyses were stratified by age (children vs adults).ResultsAdult WHtR was positively associated with urbanisation in earlier waves but became inversely associated over time. More specifically, a 1 SD increase in the urbanisation index was associated with higher WHtR by 0.002 and 0.005 in waves 1993 and 1997, while it was associated with lower WHtR by 0.001 in 2011. Among child participants, the increase in WHtR over time was predominantly observed in more urbanised communities.ConclusionOur study suggests a shift in adult abdominal adiposity from more urbanised communities to less urbanised communities over a time of rapid economic development in China. Children living in more urbanised communities had higher increase in abdominal obesity with urbanisation over time relative to children living in less urbanised communities.
Journal Article
Disordered eating and cardiometabolic risk factors in Chinese women: evidence from the China Health and Nutrition Survey
2024
Disordered eating (DE) is associated with elevated cardiometabolic risk (CMR) factors, yet little is known about this association in non-Western countries. We examined the association between DE characteristics and CMR and tested the potential mediating role of BMI. This cross-sectional study included 2005 Chinese women (aged 18–50 years) from the 2015 China Health and Nutrition Survey. Loss of control, restraint, shape concern and weight concern were assessed using selected questions from the SCOFF questionnaire and the Eating Disorder Examination-Questionnaire. Eight CMR were measured by trained staff. Generalised linear models examined associations between DE characteristics with CMR accounting for dependencies between individuals in the same household. We tested whether BMI potentially mediated significant associations using structural equation modelling. Shape concern was associated with systolic blood pressure (β (95 % CI) 0·06 (0·01, 0·10)), diastolic blood pressure (DBP) (0·07 (95 % CI 0·03, 0·11)) and high-density lipoprotein (HDL)-cholesterol (–0·08 (95 % CI –0·12, −0·04)). Weight concern was associated with DBP (0·06 (95 % CI 0·02, 0·10)), triglyceride (0·06 (95 % CI 0·02, 0·10)) and HDL-cholesterol (–0·10 (95 % CI –0·14, −0·07)). Higher scores on DE characteristics were associated with higher BMI, and higher BMI was further associated with lower HDL-cholesterol and higher other CMR. In summary, we observed significant associations between shape and weight concerns with some CMR in Chinese women, and these associations were potentially partially mediated by BMI. Our findings suggest that prevention and intervention strategies focusing on addressing DE could potentially help reduce the burden of CMR in China, possibly through controlling BMI.
Journal Article